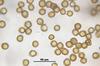

Krzywoszczeć torfowa
Campylopus pyriformis
Krzywoszczeć torfowa (Campylopus pyriformis (Schultz) Brid.) – gatunek mchu należący do rodziny widłozębowatych (Dicranaceae). Występuje w Europie, Chinach, Indiach, Mongolii, Rosji, Australii i Ameryce Północnej.
Roślina niewielkich rozmiarów, osiąga 0,5–3,5 cm wysokości. Tworzy gęste kępy koloru żółtawo zielonego do żółtawo brązowego. Łodyga wyprostowana. Liście długości 2–7 mm.
Źródło informacji: Wikipedia : wolna encyklopedia [dostęp: 2024-03-08 20:19:19]. Dostępny w internecie: https://pl.wikipedia.org/w/index.php?oldid=72327986. Główni autorzy artykułu w Wikipedii: zobacz listę.
- ogólne
- roślina chroniona